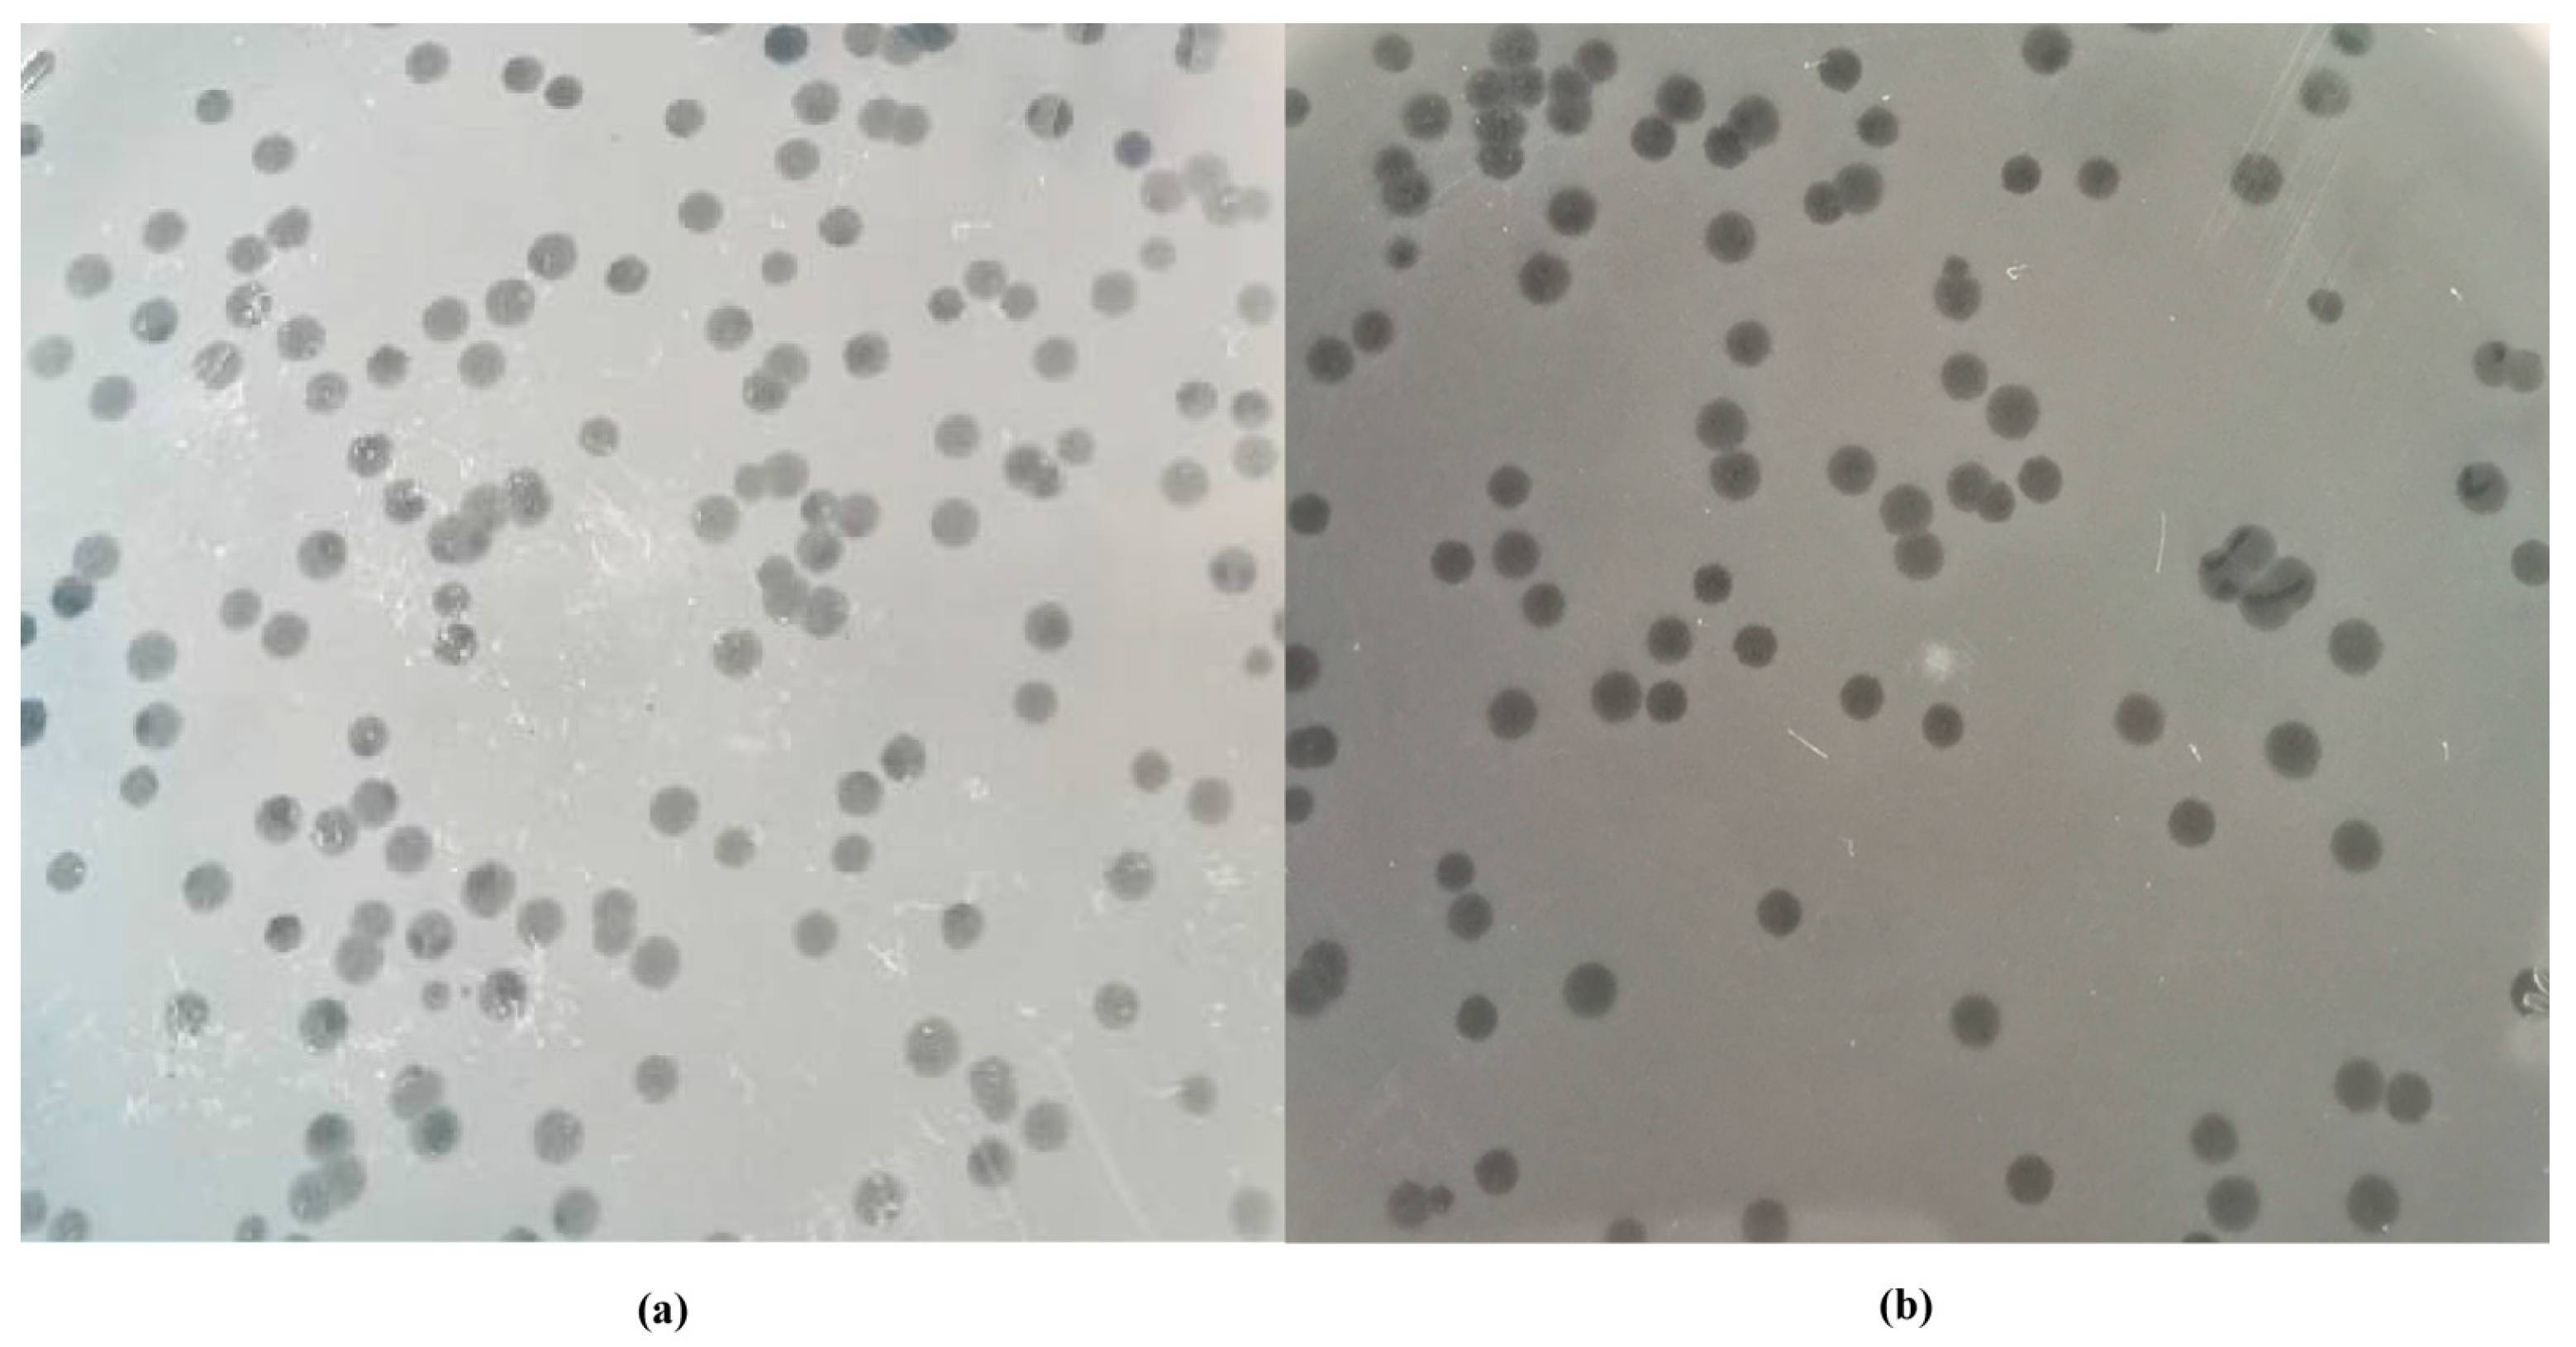
Viruses 14 02647 g001 Viruses 14 02647 g001

Broad-Spectrum Salmonella Phages PSE-D1 and PST-H1 Controls Salmonella in Foods
Abstract
1. Introduction
2. Materials and Methods
2.1. Bacteria Strains and Culture Medium
2.2. Isolation and Purification of Bacteriophages
2.3. Host Range
2.4. Characterization of Phages
2.4.1. One Step Growth
2.4.2. Lytic Capacity of Phages under Different Multiplicity of Infection (MOI)
2.4.3. Thermal and pH Stability of Phages
2.4.4. Electron Microscopy
2.4.5. Extraction and Analysis of Phage Genome Sequence
2.5. Assays on the Surface of Egg Shells, Chicken Sausage and in Fresh Milk
2.5.1. Sample Preparation
2.5.2. Salmonella and Phage Preparation
2.6. Statistical Analysis
3. Results
3.1. Isolation and Purification of Bacteriophages
3.2. Host Range
3.3. Biological Characterization of Phages
3.3.1. Electron Microscopy
3.3.2. One Step Growth
3.3.3. Lytic Capacity of Phages against Host at Different MOI
3.3.4. Thermal and pH Stability of Phages
3.4. Genomic Analysis of Phages
3.5. Application of Phages in Different Foods
3.5.1. Salmonella Reduction on Egg Shells
3.5.2. Salmonella Reduction on Sausages
3.5.3. Salmonella Reduction in Milk
4. Discussion
5. Conclusions
Supplementary Materials
Author Contributions
Funding
Institutional Review Board Statement
Informed Consent Statement
Data Availability Statement
Acknowledgments
Conflicts of Interest
References
- Brown, E.W.; Bell, R.; Zhang, G.; Timme, R.; Zheng, J.; Hammack, T.S.; Allard, M.W. Salmonella Genomics in Public Health and Food Safety. EcoSal Plus 2021, 9, eESP00082020. [Google Scholar] [CrossRef]
- European Food Safety Authority; European Centre for Disease Prevention and Control. The European Union summary report on trends and sources of zoonoses, zoonotic agents and food-borne outbreaks in 2017. EFSA J. 2018, 16, e05500. [Google Scholar]
- Centers for Disease Control and Prevention (CDC). Preliminary FoodNet data on the incidence of infection with pathogens transmitted commonly through food—10 states, United States, 2005. Jama J. Am. Med. Assoc. 2006, 295, 2241–2243, reprinted in MMWR 2006, 55, 392–395. [Google Scholar] [CrossRef][Green Version]
- Liu, D.; Gu, W.; Wang, L.; Sun, J. Photodynamic inactivation and its application in food preservation. Crit. Rev. Food Sci. Nutr. 2021, 1–15. [Google Scholar] [CrossRef]
- Ramos-Vivas, J.; Elexpuru-Zabaleta, M.; Samano, M.L.; Barrera, A.P.; Forbes-Hernández, T.Y.; Giampieri, F.; Battino, M. Phages and enzybiotics in food biopreservation. Molecules 2021, 26, 5138. [Google Scholar] [CrossRef] [PubMed]
- Ahn, D.U.; Kim, I.S.; Lee, E.J. Irradiation and additive combinations on the pathogen reduction and quality of poultry meat. Poult. Sci. 2013, 92, 534–545. [Google Scholar] [CrossRef]
- Singh, V.P. Recent approaches in food bio-preservation—A review. Open Veter J. 2018, 8, 104–111. [Google Scholar] [CrossRef] [PubMed]
- Huang, C.; Shi, J.; Ma, W.; Li, Z.; Wang, J.; Li, J.; Wang, X. Isolation, characterization, and application of a novel specific Salmonella bacteriophage in different food matrices. Food Res. Int. 2018, 111, 631–641. [Google Scholar] [CrossRef] [PubMed]
- Li, Z.; Ma, W.; Li, W.; Ding, Y.; Zhang, Y.; Yang, Q.; Wang, J.; Wang, X. A broad-spectrum phage controls multidrug-resistant Salmonella in liquid eggs. Food Res. Int. 2020, 132, 109011. [Google Scholar] [CrossRef]
- Hudson, J.; Billington, C.; Wilson, T.; On, S. Effect of phage and host concentration on the inactivation of Escherichia coli O157:H7 on cooked and raw beef. Food Sci. Technol. Int. 2013, 21, 104–109. [Google Scholar] [CrossRef]
- Xing, S.; Zhang, X.; Sun, Q.; Wang, J.; Mi, Z.; Pei, G.; Huang, Y.; An, X.; Fu, K.; Zhou, L.; et al. Complete genome sequence of a novel, virulent Ahjdlikevirus bacteriophage that infects Enterococcus faecium. Arch. Virol. 2017, 162, 3843–3847. [Google Scholar] [CrossRef] [PubMed]
- Chen, Y.; Sun, E.; Song, J.; Yang, L.; Wu, B. Complete Genome Sequence of a Novel T7-Like Bacteriophage from a Pasteurella multocida Capsular Type A Isolate. Curr. Microbiol. 2018, 75, 574–579. [Google Scholar] [CrossRef] [PubMed]
- Yoon, H.; Yun, J.; Lim, J.-A.; Roh, E.; Jung, K.-S.; Chang, Y.; Ryu, S.; Heu, S. Characterization and genomic analysis of two Staphylococcus aureus bacteriophages isolated from poultry/livestock farms. J. Gen. Virol. 2013, 94, 2569–2576. [Google Scholar] [CrossRef] [PubMed]
- Hagens, S.; Loessner, M.J. Bacteriophage for biocontrol of foodborne pathogens: Calculations and considerations. Curr. Pharm. Biotechnol. 2010, 11, 58–68. [Google Scholar] [CrossRef] [PubMed]
- Brenner, S. Physiological aspects of bacteriophage genetics. Adv. Virus Res. 1959, 6, 137–158. [Google Scholar]
- Aguilera, M.; Martínez, S.; Tello, M.; Gallardo, M.J.; García, V. Use of Cocktail of Bacteriophage for Salmonella Typhimurium Control in Chicken Meat. Foods 2022, 11, 1164. [Google Scholar] [CrossRef]
- Manohar, P.; Tamhankar, A.J.; Lundborg, C.S.; Ramesh, N. Isolation, characterization and in vivo efficacy of Escherichia phage myPSH1131. PLoS ONE 2018, 13, e0206278. [Google Scholar] [CrossRef] [PubMed]
- Kokkari, C.; Sarropoulou, E.; Bastías, R.; Mandalakis, M.; Katharios, P. Isolation and characterization of a novel bacteriophage infecting Vibrio alginolyticus. Arch. Microbiol. 2018, 200, 707–718. [Google Scholar] [CrossRef]
- Lam, H.Y.P.; Peng, S.Y.; Paramita, P.; Wu, W.J.; Chen, L.K.; Chao, H.J.; Lai, M.J.; Chang, K.C. Biological and genomic characterization of two newly isolated Elizabethkingia anophelis bacteriophages. J. Microbiol. Immunol. Infect. 2022, 55, 634–642. [Google Scholar]
- Lu, S.; Le, S.; Tan, Y.; Zhu, J.; Li, M.; Rao, X.; Zou, L.; Li, S.; Wang, J.; Jin, X.; et al. Genomic and Proteomic Analyses of the Terminally Redundant Genome of the Pseudomonas aeruginosa Phage PaP1: Establishment of Genus PaP1-Like Phages. PLoS ONE 2013, 8, e62933. [Google Scholar] [CrossRef]
- Liu, B.; Zheng, D.; Jin, Q.; Chen, L.; Yang, J. VFDB 2019: A comparative pathogenomic platform with an interactive web interface. Nucleic Acids Res. 2018, 47, D687–D692. [Google Scholar] [CrossRef] [PubMed]
- Jia, B.; Raphenya, A.R.; Alcock, B.; Waglechner, N.; Guo, P.; Tsang, K.K.; Lago, B.A.; Dave, B.M.; Pereira, S.; Sharma, A.N.; et al. CARD 2017: Expansion and model-centric curation of the comprehensive antibiotic resistance database. Nucleic Acids Res. 2017, 45, D566–D573. [Google Scholar] [CrossRef] [PubMed]
- Kumar, S.; Stecher, G.; Li, M.; Knyaz, C.; Tamura, K. MEGA X: Molecular Evolutionary Genetics Analysis across Computing Platforms. Mol. Biol. Evol. 2018, 35, 1547–1549. [Google Scholar] [CrossRef] [PubMed]
- Hudson, J.; Billington, C.; Cornelius, A.; Wilson, T.; On, S.; Premaratne, A.; King, N. Use of a bacteriophage to inactivate Escherichia coli O157:H7 on beef. Food Microbiol. 2013, 36, 14–21. [Google Scholar] [CrossRef] [PubMed]
- Wang, C.; Chen, Q.; Zhang, C.; Yang, J.; Lu, Z.; Lu, F.; Bie, X. Characterization of a broad host-spectrum virulent Salmonella bacteriophage fmb-p1 and its application on duck meat. Virus Res. 2017, 236, 14–23. [Google Scholar] [CrossRef]
- McLean, S.K.; Dunn, L.A.; Palombo, E.A. Phage Inhibition of Escherichia coli in Ultrahigh-Temperature-Treated and Raw Milk. Foodborne Pathog. Dis. 2013, 10, 956–962. [Google Scholar] [CrossRef]
- Luo, D.D.; Li, C.S.; Wu, Q.P.; Ding, Y.; Yang, M.Y.; Hu, Y.D.; Zeng, H.; Zhang, J. Isolation and characterization of new phage vB_CtuP_A24 and application to control Cronobacter spp. in infant milk formula and lettuce. Food Res. Int. 2021, 141, 110109. [Google Scholar] [CrossRef]
- Sritha, K.S.; Bhat, S.G. In vitro efficiency evaluation of phage cocktail for biocontrol of Salmonella spp. in food products. Arch. Microbiol. 2021, 203, 5445–5452. [Google Scholar]
- Oppenheim, A.B.; Kobiler, O.; Stavans, J.; Court, D.L.; Adhya, S. Switches in Bacteriophage Lambda Development. Annu. Rev. Genet. 2005, 39, 409–429. [Google Scholar] [CrossRef]
- Burda, M.R.; Hindennach, I.; Miller, S. Stability of Bacteriophage T4 Short Tail Fiber. Biol. Chem. 2000, 381, 255–258. [Google Scholar] [CrossRef]
- Feng, X.; Yan, W.; Wang, A.; Ma, R.; Chen, X.; Lin, T.-H.; Chen, Y.-L.; Wei, S.; Jin, T.; Jiao, N.; et al. A Novel Broad Host Range Phage Infecting Alteromonas. Viruses 2021, 13, 987. [Google Scholar] [CrossRef]
- Naknaen, A.; Suttinun, O.; Surachat, K.; Khan, E.; Pomwised, R. A Novel Jumbo Phage PhiMa05 Inhibits Harmful Microcystis sp. Front. Microbiol. 2021, 12, 660351. [Google Scholar] [CrossRef]
- Wang, R.; Xing, S.; Zhao, F.; Li, P.; Mi, Z.; Shi, T.; Liu, H.; Tong, Y. Characterization and genome analysis of novel phage vB_EfaP_IME195 infecting Enterococcus faecalis. Virus Genes 2018, 54, 804–811. [Google Scholar] [CrossRef] [PubMed]
- Chen, L.; Liu, Q.; Fan, J.; Yan, T.; Zhang, H.; Yang, J.; Deng, D.; Liu, C.; Wei, T.; Ma, Y. Characterization and Genomic Analysis of ValSw3-3, a New Siphoviridae Bacteriophage Infecting Vibrio alginolyticus. J. Virol. 2020, 94, e00066-20. [Google Scholar] [CrossRef] [PubMed]
- Grace, D.; Wu, F.; Havelaar, A.H. MILK Symposium review: Foodborne diseases from milk and milk products in developing countries-Review of causes and health and economic implications. J. Dairy Sci. 2020, 103, 9715–9729. [Google Scholar] [CrossRef] [PubMed]
- Bao, H.; Zhang, P.; Zhang, H.; Zhou, Y.; Zhang, L.; Wang, R. Bio-Control of Salmonella Enteritidis in Foods Using Bacteriophages. Viruses 2015, 7, 4836–4853. [Google Scholar] [CrossRef] [PubMed]
- Phongtang, W.; Choi, G.-P.; Chukeatirote, E.; Ahn, J. Bacteriophage control of Salmonella Typhimurium in milk. Food Sci. Biotechnol. 2018, 28, 297–301. [Google Scholar] [CrossRef]
- Olsen, S.J.; Ying, M.; Davis, M.F.; Deasy, M.; Holland, B.; Iampietro, L.; Baysinger, C.M.; Sassano, F.; Polk, L.D.; Gormley, B.; et al. Multidrug-resistant Salmonella Typhimurium Infection from Milk Contaminated after Pasteurization. Emerg. Infect. Dis. 2004, 10, 932–935. [Google Scholar] [CrossRef]
- Wessels, K.; Rip, D.; Gouws, P. Salmonella in Chicken Meat: Consumption, Outbreaks, Characteristics, Current Control Methods and the Potential of Bacteriophage Use. Foods 2021, 10, 1742. [Google Scholar] [CrossRef]
- Messens, W.; Grijspeerdt, K.; Herman, L. Eggshell characteristics and penetration by Salmonella enterica serovar Enteritidis through the production period of a layer flock. Br. Poult Sci. 2005, 46, 694–700. [Google Scholar] [CrossRef]
- Sharma, M. Lytic bacteriophages: Potential interventions against enteric bacterial pathogens on produce. Bacteriophage 2013, 3, e25518. [Google Scholar] [CrossRef] [PubMed]
- Kim, J.H.; Kim, H.J.; Jung, S.J.; Mizan, M.F.R.; Park, S.H.; Ha, S.D. Characterization of Salmonella spp.-specific bacteriophages and their biocontrol application in chicken breast meat. J. Food Sci. 2020, 85, 526–534. [Google Scholar] [CrossRef] [PubMed]

| Strain Type | Strain Name | Place | Source | Sampling Method | Serotype | PST-H1 Lysis | PSE-D1 Lysis |
|---|---|---|---|---|---|---|---|
| Salmonella | CVCC3384 | CVCC | Pig | CVCC | S. Typhimurium | + | + |
| Salmonella | CVCC1806 | CVCC | Avian | CVCC | S. Enteritidis | + | + |
| Salmonella | SX-1014 | CVCC | Avian | CVCC | S. Pullorum | − | − |
| Salmonella | SF-0923 | CVCC | Avian | CVCC | S. Pullorum | + | + |
| Salmonella | GXSE-S7 | Guangxi | Pig | Intestine | O2, -: Ha: - | − | − |
| Salmonella | GXSE-S4 | Guangxi | Pig | Intestine | O7, -: Hc: - | − | − |
| Escherichia coli | GDEC-8 | Guangdong | Pig | Anal swab | Undetected | − | + |
| Escherichia coli | GDEC-9 | Guangdong | Pig | Anal swab | Undetected | − | + |
| Escherichia coli | GDEC-10 | Guangdong | Pig | Anal swab | Undetected | − | − |
| Escherichia coli | GDEC-11 | Guangdong | Pig | Anal swab | Undetected | − | − |
| Escherichia coli | GDEC-12 | Guangdong | Pig | Anal swab | Undetected | − | − |
| Escherichia coli | GDEC-13 | Guangdong | Pig | Anal swab | Undetected | − | − |
| Escherichia coli | GDEC-14 | Guangdong | Pig | Anal swab | Undetected | − | + |
| Escherichia coli | GDEC-19 | Guangdong | Pig | Anal swab | Undetected | − | + |
| Escherichia coli | GDEC-20 | Guangdong | Pig | Anal swab | O127a: K63 (B8) | − | − |
| Escherichia coli | GDEC-27 | Guangdong | Pig | Anal swab | Undetected | − | + |
| Escherichia coli | GDEC-28 | Guangdong | Pig | Anal swab | O127a: K63 (B8) | − | + |
| Escherichia coli | GDEC-33 | Guangdong | Pig | Anal swab | Undetected | + | − |
| Escherichia coli | GDEC-34 | Guangdong | Pig | Anal swab | Undetected | + | − |
| Escherichia coli | GDEC-35 | Guangdong | Pig | Anal swab | Undetected | − | − |
| Escherichia coli | GDEC-45 | Guangdong | Pig | Anal swab | Undetected | + | − |
| Escherichia coli | GDEC-46 | Guangdong | Pig | Anal swab | Undetected | + | − |
| Escherichia coli | SCEC-6 | Sichuan | Avian | Intestine | Undetected | − | − |
| Escherichia coli | SCEC-7 | Sichuan | Avian | Intestine | Undetected | + | − |
| Escherichia coli | SCEC-12 | Sichuan | Avian | Intestine | Undetected | − | − |
| Escherichia coli | SCEC-13 | Sichuan | Avian | Intestine | Undetected | − | − |
| Escherichia coli | SCEC-14 | Sichuan | Avian | Intestine | Undetected | − | − |
| Escherichia coli | SCEC-15 | Sichuan | Avian | Intestine | Undetected | − | − |
| Escherichia coli | SCEC-16 | Sichuan | Avian | Intestine | Undetected | + | − |
| Escherichia coli | GXEC-1 | Guangxi | Avian | Intestine | Undetected | − | − |
| Escherichia coli | GXEC-2 | Guangxi | Avian | Intestine | Undetected | − | − |
| Escherichia coli | GXEC-3 | Guangxi | Avian | Intestine | Undetected | − | + |
| Escherichia coli | GXEC-4 | Guangxi | Avian | Intestine | Undetected | − | − |
| Escherichia coli | GXEC-5 | Guangxi | Avian | Intestine | Undetected | − | + |
| Escherichia coli | GXEC-6 | Guangxi | Avian | Intestine | Undetected | − | − |
| Escherichia coli | GXEC-7 | Guangxi | Avian | Intestine | Undetected | − | + |
| Escherichia coli | GXEC-64 | Guangxi | Human | Anal swab | Undetected | − | + |
| Escherichia coli | GXEC-65 | Guangxi | Human | Anal swab | O86: K61 (B7) | − | − |
| Escherichia coli | GXEC-66 | Guangxi | Human | Anal swab | O86: K61 (B7) | − | + |
| Escherichia coli | GXEC-74 | Guangxi | Human | Anal swab | Undetected | − | + |
| Escherichia coli | GXEC-75 | Guangxi | Human | Anal swab | Undetected | − | + |
| Escherichia coli | GXEC-80 | Guangxi | Human | Anal swab | Undetected | − | − |
| Escherichia coli | GXEC-81 | Guangxi | Human | Anal swab | Undetected | + | − |
| Escherichia coli | FJEC-1 | Fujian | Human | Anal swab | Undetected | − | − |
| Escherichia coli | FJEC-2 | Fujian | Human | Anal swab | Undetected | − | − |
| Escherichia coli | FJEC-3 | Fujian | Human | Anal swab | Undetected | − | − |
| Escherichia coli | FJEC-4 | Fujian | Human | Anal swab | Undetected | − | − |
| Escherichia coli | FJEC-5 | Fujian | Human | Anal swab | Undetected | + | − |
| Escherichia coli | FJEC-6 | Fujian | Human | Anal swab | Undetected | − | − |
| Escherichia coli | FJEC-7 | Fujian | Human | Anal swab | Undetected | + | − |
| Escherichia coli | FJEC-8 | Fujian | Human | Anal swab | Undetected | − | − |
| Escherichia coli | FJEC-9 | Fujian | Human | Anal swab | Undetected | − | − |
| Escherichia coli | FJEC-10 | Fujian | Human | Anal swab | Undetected | − | − |
| Escherichia coli | FJEC-11 | Fujian | Human | Anal swab | Undetected | + | − |
| Klebsiella pneumoniae | GXKP-6 | Guangxi | Human | Anal swab | Undetected | − | + |
| Klebsiella pneumoniae | GXKP-13 | Guangxi | Human | Anal swab | Undetected | + | + |
| Klebsiella pneumoniae | GXKP-20 | Guangxi | Human | Anal swab | Undetected | + | − |
| Klebsiella pneumoniae | GXKP-21 | Guangxi | Human | Anal swab | Undetected | − | + |
| Klebsiella pneumoniae | GXKP-49 | Guangxi | Human | Anal swab | Undetected | + | + |
| Klebsiella pneumoniae | GXKP-RS3 | Guangxi | Human | Anal swab | Undetected | − | + |
| Klebsiella pneumoniae | GXKP-L3 | Guangxi | Human | Anal swab | Undetected | − | − |
| Klebsiella pneumoniae | GXKP-L11 | Guangxi | Human | Anal swab | Undetected | + | − |
| Klebsiella pneumoniae | GXKP-L15 | Guangxi | Human | Anal swab | Undetected | + | − |
| Klebsiella pneumoniae | GXKP-L28 | Guangxi | Human | Anal swab | Undetected | + | − |
| Klebsiella pneumoniae | GXKP-L30 | Guangxi | Human | Anal swab | Undetected | + | + |
| Klebsiella pneumoniae | GXKP-L34 | Guangxi | Human | Anal swab | Undetected | + | − |
| Klebsiella pneumoniae | GXKP-L40 | Guangxi | Human | Anal swab | Undetected | + | + |
| Klebsiella pneumoniae | GXKP-L44 | Guangxi | Human | Anal swab | Undetected | + | − |
| Klebsiella pneumoniae | GXKP-L45 | Guangxi | Human | Anal swab | Undetected | + | + |
| Pseudomonas aeruginosa | SZPA-1 | Guangdong | Dog | Skin | Undetected | − | − |
Publisher’s Note: MDPI stays neutral with regard to jurisdictional claims in published maps and institutional affiliations. |
© 2022 by the authors. Licensee MDPI, Basel, Switzerland. This article is an open access article distributed under the terms and conditions of the Creative Commons Attribution (CC BY) license (https://creativecommons.org/licenses/by/4.0/).
Share and Cite
Cao, Y.; Ma, R.; Li, Z.; Mao, X.; Li, Y.; Wu, Y.; Wang, L.; Han, K.; Li, L.; Ma, D.; et al. Broad-Spectrum Salmonella Phages PSE-D1 and PST-H1 Controls Salmonella in Foods. Viruses 2022, 14, 2647. https://doi.org/10.3390/v14122647
Cao Y, Ma R, Li Z, Mao X, Li Y, Wu Y, Wang L, Han K, Li L, Ma D, et al. Broad-Spectrum Salmonella Phages PSE-D1 and PST-H1 Controls Salmonella in Foods. Viruses. 2022; 14(12):2647. https://doi.org/10.3390/v14122647
Chicago/Turabian StyleCao, Yajie, Runwen Ma, Ziyong Li, Xinyu Mao, Yinan Li, Yuxin Wu, Leping Wang, Kaiou Han, Lei Li, Dongxin Ma, and et al. 2022. "Broad-Spectrum Salmonella Phages PSE-D1 and PST-H1 Controls Salmonella in Foods" Viruses 14, no. 12: 2647. https://doi.org/10.3390/v14122647
APA StyleCao, Y., Ma, R., Li, Z., Mao, X., Li, Y., Wu, Y., Wang, L., Han, K., Li, L., Ma, D., Zhou, Y., Li, X., & Wang, X. (2022). Broad-Spectrum Salmonella Phages PSE-D1 and PST-H1 Controls Salmonella in Foods. Viruses, 14(12), 2647. https://doi.org/10.3390/v14122647

